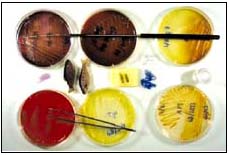

Tore Håstein and Roar Gudding
National Veterinary
Institute
Oslo, Norway
[email protected]
[email protected]
Håstein, T. & Gudding, R. 2005. Emergency preparedness of aquatic animal diseases: Norwegian experiences. p. 79–85. In: Subasinghe, R.P.; Arthur, J.R. (eds.). Regional workshop on preparedness and response to aquatic animal health emergencies in Asia. Jakarta, Indonesia, 21–23 September 2004. FAO Fisheries Proceedings. No. 4. Rome, FAO. 2005. 178p.
ABSTRACT
Outbreaks of disease may have large consequences for aquaculture production and thus significant impact on the economy at the local, regional and national levels. This paper describes the key elements in emergency preparedness based on Norwegian experiences. Norway has had fish disease legislation since 1968. Management of disease emergencies is a core responsibility of governmental authorities based on appropriate legislation. Regulations on notification, diagnosis, epidemiology and restrictions on trade as well as fallowing and disinfection are important tools in disease management. An effective organization and adequate personnel resources, as well as competent diagnostic laboratories, are also key elements. Furthermore, emergency preparedness includes disease prevention and control through implementation of factors such as movement control, sanitary slaughter and zoning. With the tools described, it is possible to handle emergencies in aquaculture optimally.
INTRODUCTION
Over the last decades, emerging or serious diseases such as viral haemorrhagic septicaemia (VHS), infectious haematopoietic necrosis (IHN), infectious pancreatic necrosis (IPN), viral nervous necrosis (VNN), epizootic ulcerative syndrome (EUS) and many others have been diagnosed in feral and farmed fish populations in different parts of the world where they were previously unknown to occur.
Outbreaks of severe disease may have dramatic consequences for aquaculture production and thus have significant impact on the economy at the local, regional and national levels. The losses may be due to reduced production, increased labour costs and increased expenses due to medication. In addition, restrictions on trade are becoming increasingly important as an economic consequence. Furthermore, diseases in farmed aquatic animals may affect the environment in different ways, for instance by transmission of infectious disease to the wild fish population, which may have a negative impact on the wild stock, e.g. infection of Gyrodactylus salaris in Norwegian rivers.

Gyrodactylus salaris of salmon
The food safety aspect of diseases of aquatic animals is less important than for diseases in terrestrial animals, as few aquatic animal diseases have true zoonotic potential. However, as microbial diseases in farmed fish are often treated with antibiotics, both residues and microbial resistance against antibiotics may be undesired effects of fish disease.
Effective emergency management is therefore crucial in order to reduce the economic, social and environmental impacts of serious diseases in aquaculture, and many countries, including Norway, have thus initiated emergency programmes for the control and/or eradication of such diseases (Folkestad and Torgersen 1999, Håstein, Hill and Winton 1999). The efficiency and success of such programmes are dependent on rapid initiation of the necessary measures/actions.
DISEASE AETIOLOGY
The most serious diseases in aquatic animals are caused by micro-organisms (bacteria, fungi, viruses, parasites). Such diseases may be introduced to a region/country, while others may already exist, but show a rapid increase in incidence due to predisposing factors such as high population density, bad water quality etc. The nature of the diseases, including their contagiousness and severity, may, however, vary significantly. Non-infectious diseases due to toxic components or nutritional factors may also have severe impact in aquaculture. Diseases with complex aetiology, involving both microorganisms as well as various predisposing factors, are becoming more common in some countries with a developed aquaculture.
RESPONSIBILITY
The management of disease emergencies remains a core responsibility for governmental authorities. The government should provide the necessary legislation and should also have an important role in leadership and intellectual input in such work. However, cooperation with the private sector, for example industrial organizations, local enterprises and farmers, is also an important element in the management of emergencies.
In Norway, the Ministry of Agriculture has had responsibility for aquatic animal diseases since 1968. As of 2004, the Ministry of Fisheries took over this responsibility as part of the reorganization of legislation related to food safety and the health of animals, aquatic animals and plants. A new agency, the Norwegian Food Safety Authority, has responsibility for implementing the Act and regulations given in pursuance of the Act.
LEGISLATION
Appropriate legislation is a fundamental instrument in emergency management. All biosecurity measures must have a legal basis. This includes disease notification, disease diagnosis or suspicion of disease, collection of specimens or epidemiological information, restrictions on trade or movement, disposal and decontamination of material, and cleaning and disinfection of premises.
The statutory definition of action to be taken is one of the most significant legal steps for disease control in aquatic animals and may have tremendous implications for on-farm management practices aimed at disease control. Depending upon the classification and importance of a notifiable disease, different management practises may be laid down by law to achieve sufficient disease control.
In Norway, fish disease legislation was established in 1968 due to the introduction of serious diseases such as viral haemorrhagic septicaemia (VHS) and furunculosis into Norway by imports of live rainbow trout (Oncorhynchus mykiss) from Denmark (Håstein, Holt and Krogsrud 1968, Holt and Håstein 1970).
The first “Fish Disease Act”covered only diseases of freshwater fish, including anadromous and catadromous fish species as well as freshwater crayfish. The reason for this was that diseases in salmonid species and freshwater crayfish were of major importance, and farming of other species had not been considered at that time.
In 1990, an interim Act covering all aquatic organisms, including marine species, was adopted. However, as regards marine aquatic organisms, only those kept under culture conditions were covered. The intention was to replace this interim Act by a permanent Act in 1992, but this permanent Act did not come into force until 1997.
As of January 2004, a new legislation, the so-called “Food Act”, covering all aspects of animals and aquatic animals from fiord and pasture to the table was introduced (Anon., 2004a).
Several regulations have been introduced in pursuance of the acts referred to above, and these regulations have been improved over the years since 1968 until today. Some 36 regulations are now in force in pursuance of the current Act.
The “Food Act”is an enabling act as regards control of animal health and gives wide authority to prevent, eradicate and keep diseases and infective agents in aquatic animals under surveillance. The Act also includes particular powers to ensure eradication of exotic diseases.
ORGANIZATION
An effective organization with functional responsibilities for preparedness is the basis for the work of the governmental authority. In addition to a central unit with direct link to the policy decision-makers within the political system, including those at the ministerial level, there should be a regional and a local organization with professional and paraprofessional personnel. The command principles between the levels of the organization, as well as the relationship to institutions providing scientific and technical support, should be well defined. As cooperation with the industry and information to the public are important for the success of any emergency management, a well-organized communications system should be integrated into the organization.
In Norway, the Norwegian Food Safety Authority consists of three levels: a Central Unit, eight Regional Offices and 64 District Offices covering the entire country. In emergency situations, the District Offices have the main responsibility for immediate implementation of measures such as:
repeal of restrictions.
The tasks of the District Offices include reporting to the regional and central authorities.
PERSONNEL RESOURCES
Depending on the infrastructure within a country, a national and/or a regional (local) emergency team (disease experts, operational team, administrative personnel) should be established in order to cope with outbreaks of serious diseases.
In Norway, we have a network of veterinarians, fish health biologists and diagnostic laboratories that may be involved in implementation of actions necessitated by an emergency disease outbreak. With such a good infrastructure, it has been relatively easy to implement any information and measures to be taken in case of an outbreak of an unknown disease.
TRAINING PROGRAMMES

TORE HÅSTEIN
Fish health training
In order to maintain the state of readiness, announced and unannounced exercises in handling exotic diseases or any serious disease should be carried out for personnel at all levels that will become involved in the different aspects of control of aquatic animal diseases. For fish health personnel, this must include updated information on the disease in question, epidemiology of the disease, sampling and diagnostic methods, new disinfection procedures etc. Specific training programmes should also involve people from the fish farming industry. The responsibility for these training programmes should involve the responsible authorities at the central, regional and local levels. Norway has good experience with such types of training programmes.
EQUIPMENT AND FACILITIES
Handling of emergency situations requires necessary equipment and supplies. These include communication equipment and maps covering coastal and continental areas of the country, as well as equipment for necropsy and the introduction of sanitary measures. Furthermore, routines for how to issue warning notices to inform the public relating to restricted access to the premises in question, as well as access to transportation units (boats, vehicles) are needed and whether sanitary slaughtering, etc. is required. All this will have to be a part of a contingency plan.
MANUAL
Preparation for emergency situations is crucial for success during a disease crisis. A simple but thoroughly written plan describing responsibilities and activities in case of a disease outbreak is a major element in the emergency management. Professional and paraprofessional personnel with theoretical and practical training must be available in order to carry out the activities at the central and regional units, as well as on the local level.
Although Norway, presently has in force only a contingency plan for infectious salmon anaemia (ISA) (Anon., 2004b), the principles laid down in this plan have also been used to bring other serious diseases under control.
DIAGNOSTIC LABORATORIES
Rapid, reliable and effective diagnostic work should be carried out by national or provincial laboratories designated for such purposes by the competent authority, as this may be essential for a successful outcome of a crisis. Diagnoses of serious disease should, if necessary, be confirmed by an international reference laboratory for the disease in question.
TORE HÅSTEIN
Bacteriological analysis
Each country should thus establish a national fish disease reference laboratory that should have a key responsibility for aquatic animal diseases and with well-qualified personnel, facilities and equipment in order to handle a crisis. This responsibility should include reference functions for regional and local laboratories with official or private funding. A decentralized laboratory structure is especially essential in countries with large fish populations that are distributed over large geographical areas.

TORE HÅSTEIN
Microbiology laboratory
The expertise of the laboratories should include scientifically based diagnostic procedures in addition to research, but also competence in preventive medicine and emergency management is needed. Descriptive and analytical epidemiology and risk assessment are areas with increasing significance in emergency situations in aquaculture and should be part of the scientific advice given to the authorities by the laboratories.
New methods for diagnostic work and surveillance are under continuous development, and the laboratory should have the competence and capacity to be updated on the international progress in diagnostic procedures.
Pathology is considered as the most essential area of competence for an aquatic animal health laboratory with diagnostic responsibilities. The clinical signs in diseased aquatic animals are often vague and non-specific, and necropsy is the major method for diagnosing diseases. The post-mortem lesions should be supported by histological examinations. Techniques based on histochemistry and immunological methods may contribute to a more precise diagnosis, including the aetiology of a given disease.
Necropsy should be performed in an equipped laboratory with good technical support. However, if transport to a pathological laboratory is long and costly, necropsy in the field may be an alternative. If performed by skilled personnel, a preliminary diagnosis may be obtained, creating a basis for control measures. Furthermore, samples may be taken, preserved and shipped to regional or central laboratories for further examination and confirmation.
Bacteriological examinations should be available in any diagnostic laboratory. Diagnostics for viral diseases requires cell or tissue cultures and personnel with special expertise. Viral isolation should consequently be performed in the central and most specialized laboratories.
Methods based on molecular biology are becoming more and more used as part of the diagnostic work in bacteriology, virology, mycology and parasitology. These techniques offer great advantages in sensitivity and speed, but the analyses should take place in well-equipped laboratories due to the risk of false positive and negative reactions.
Over the years, the National Veterinary Institute has built up its expertise in all the fields mentioned above and functions as a national reference laboratory for Norway, giving scientific advice to the authorities based upon research, surveillance programmes and the results of diagnostic investigations.
COMMUNICATION
Since most aquatic animal diseases constitute no human health hazard, it may not be necessary to direct special efforts towards public education. Nevertheless, it may be worth while to prepare some press releases giving definite information on the disease in question to avoid rumours and incorrect information. Such information should clearly state that the disease does not represent any health risks to humans.
However, from an aquatic animal disease aspect, there is a need for emergency information between the field and the international society when a listed disease has been diagnosed. Thus, neighbouring countries should be informed, in addition to international organizations (i.e. the European Union (EU), the Network of Aquaculture Centres in Asia-Pacific (NACA), the Office International des Épizooties (OIE) etc.).

Effect of vaccination on the use of antibacterials in Norway 1974 – 2003
DISEASE PREVENTION AND CONTROL
Emergency preparedness for aquatic animal diseases also includes establishment of disease prevention and control measures. Since production of animal protein has to be sustainable, the preventive measures to be used have to be acceptable from a biological and environmental point of view. Vaccination is now the single most important measure for prevention of bacterial diseases in farmed fish, especially in salmonid fish (Håstein, Gudding and Evensen, 2005).
In Norway, the use of vaccination as a preventive measure started as early as 1977, and regulations regarding vaccination of fish were established in 1983. These regulations were updated in 1999 (Anon., 1999). Only vaccines authorized by the Norwegian Medicinal Authority are allowed to be used. The vaccination policy in Norway has had a large influence on the use of antibacterials.
Effective control of an emerging disease may be obtained through implementation of measures such as movement restriction, stamping out, sanitary slaughter and establishment of control and surveillance zones.
CONCLUSIONS
Based on the experiences gained in Norway after some 35 years of disease control in aquatic animals, we still have to live with certain diseases, but the legislation and regulations have given us the necessary tools to handle emergency crises in an optimal way. Since the infrastructure and disease situation may vary from country to country and between regions, it is important that the regulations are as flexible as possible in order to retain sufficient precautions should an emergency situation occur.
LITERATURE CITED
Anon. 1999. Regulations of 20th December 1999 No. 1310 relating to vaccination of domestic animals, wildlife, fish and other aquatic animals (The regulations of vaccination).
Anon. 2004a. Lov 2003-12-19 nr 124: Lov om matproduksjon og mattrygghet mv. (matloven). [Act of 19th December 2003 No. 124 relating to food production and food safety (“The Food Act”)] (In Norwegian).
Anon. 2004b. Contingency plan for control of infectious salmon anaemia (ISA) in Norway.
Folkestad, P. & Torgersen, Y. 1999. Disease prevention and control in aquatic animals from a legislative point of view with special reference to Norwegian experiences. 9 pp. Presentation at the Second Workshop of the National Coordinators. FAO/NACA/OIE Regional Programme for the Development of Technical Guidelines on Quarantine and Health Certification and Establishment of Information Systems for the Responsible Movement of Live Aquatic Animals in Asia. Bangkok, 1–5 February 1999.
Håstein, T., Gudding, R. & Evensen, Ø. 2005. Bacterial vaccines for fish; an update of the current situation world wide. In: Fish Vaccinology. Developments in Biological Standardisation. (In press).
Håstein, T., Hill, B.J. & Winton, J.R. 1999. Successful aquatic animal disease emergency programmes. Rev. Sci. Tech. Off. Int. Epiz., 18: 214–227.
Håstein, T., Holt, G. & Krogsrud, J. 1968. Hemorrhagisk virusseptikemi (Egtvedsyke) hos regnbueørret i Norge. [Haemorrhagic viral septicaemia in rainbow trout in Norway.] Nord. Vet., 20: 708–711. (In Norwegian, English summary).
Holt, G. & Håstein, T. 1970. Furunkulose hos fisk i Norge [Furunculosis in fish in Norway.] Nord. Vet., 22: 505–509. (In Norwegian, English summary).
Agus Sunarto
Fish Health Research
Laboratory
Jl. Ragunan No. 20
Jakarta 12540,
Indonesia
[email protected]
Angus Cameron
AusVet Animal Health
Services
140 Falls Road
Wentworth Falls NSW 2782, Australia
[email protected]
Sunarto, A. & Cameron, A. 2005. Response to mass mortality of carp: an Indonesian experience. p. 87–105. In: Subasinghe, R.P.; Arthur, J.R. (eds.). Regional workshop on preparedness and response to aquatic animal health emergencies in Asia. Jakarta, Indonesia, 21–23 September 2004. FAO Fisheries Proceedings. No. 4. Rome, FAO. 2005. 178p.
ABSTRACT
Since March 2002, Indonesian carp culture has faced a serious epizootic that has caused severe economic loss and significant social impact. As of December 2003, losses were estimated at US$15 million, with total fish mortality of up to 80–95 percent. The disease outbreaks affected koi and common carp (Cyprinus carpio) populations of all ages and sizes cultured in different grow-out facilities (ponds, lakes, cages etc.), regardless of stocking density. Epidemiological observations indicated that the first outbreak occurred in imported koi carp that had just been transported from Surabaya to Blitar, both in East Java. The heavy rain prior to the initial outbreak indicated the possibility of an environmental triggering factor, such as temperature. Based on the history, clinical signs, epidemiological features, histopathological changes, results of experimental infection, PCR detection of naturally and experimentally diseased fish, and analysis of DNA sequence, it is confirmed that Koi herpes virus (KHV) was involved in this serious outbreak. To prevent the spread of the disease to other islands, the Government of Indonesia declared the islands of Java and Bali as isolated areas infected with the disease, and movement of koi and common carps from Java to other islands has been restricted to quarantined animals. The government has also taken measures to reduce the possible re-introduction of the disease through importation of koi and common carps into the country. This paper includes information collected in July 2002 during the initial investigation conducted by the Emergency Disease Control Task Force on a Serious Disease of Koi and Common Carps in Indonesia organized by the Network of Aquaculture Centres in Asia-Pacific (NACA) and partners, results of the on-going work undertaken by the National Disease Task Force, and the Food and Agriculture Organization of the United Nations'(FAO) follow-up assistance through a Technical Cooperation Project.
INTRODUCTION
Aquaculture plays an important role in rural development, provides a source for export earning and has proved to be a leading sector in economic growth in Indonesia. Freshwater, brackishwater, and marine cage culture still have an opportunity to be expanded and developed. However, since March 2002, Indonesian carp culture has faced a serious epizootic that has caused severe economic loss and significant social impact. The epizootic nature of the disease and its potential for spread to neighbouring Asian countries, the current economic impact and the potential threat to the production of this important foodfish, and the potential trade and economic implications are significant and require urgent implementation of containment and control procedures.
Responding to an official request from the Government of Indonesia, immediate assistance was provided by the Network of Aquaculture Centres in Asia-Pacific (NACA) and partners, by fielding an Emergency Disease Control Task Force on a Serious Disease of Koi and Common Carps in Indonesia consisting of three fish health experts in July 2002. The Task Force provided several key recommendations to improve the fish health status of Indonesia and to reduce possible disease outbreaks. The Task Force report provides supportive evidence of possible Koi herpes virus (KHV) infection, the confirmed aetiology of which is yet to be found. To further assist Indonesia in finding a resolution to this emergency situation, the Food and Agriculture Organization of the United Nations (FAO) approved emergency assistance to the Government of Indonesia through a Technical Cooperation Project - TCP/INS/2905(A) entitled “Health Management in Freshwater Aquaculture”, which commenced on 10 January 2003.
This paper includes vital information collected in July 2002 during the initial investigation conducted by the Emergency Task Force organized by NACA and partners, results of the on-going work undertaken by the National Disease Task Force, and FAO's follow-up assistance through a Technical Cooperation Project.
EMERGENCY RESPONSE
The Government of Indonesia immediately responded to the outbreak of mass mortality of koi and common carp. Initial actions taken included announcing the occurrence of the disease outbreak to stakeholders, issuing a regulation restricting the movement of diseased fish, organizing the National Disease Task Force, reporting the outbreak to the Office International des Épizooties (OIE) (Rukyani, 2002), and seeking assistance from international agencies that lead to the formation of NACA's Task Force and an FAO Technical Cooperation Project. In addition, the government also provided various assistances to affected carp farmers.

AGUS SUNARTO
Koi carps are highly valuble ornamental fish
Rules and regulations
The first episode of the outbreak in koi occurred in March 2002 in Blitar, East Java. On 17 May 2002, the Director General of Aquaculture (DGA) issued Circulation Letter No. 1874 pertaining to the disease outbreak in koi and common carp. The announcement letter was circulated to provincial governments, fisheries offices and other stakeholders. As the outbreak was escalating and spreading to new areas, the government organized a National Disease Task Force (DGA's Letter No. 2101 dated 4 June 2002). The main mandate of the National Task Force is to control the outbreak and to minimize the economic losses.

AGUS SUNARTO
Common carps are important food fish
Based on the recommendation of the National Task Force, the government declared Java Island as an isolated area of the disease, strictly prohibited the movement of koi and common carp from Java to other islands, and permitted the importation of koi and common carp only from KHV-free countries (DGA's Letter No. 2317 dated 14 June 2002 and Ministerial Decree No. 28 dated 2 July 2002). The regulations were issued in order to protect the country from re-introduction of the disease, to prevent wider spread of KHV and to minimize losses in common carp and koi culture. However, due to the restriction on movement of koi and common carp, there was an over-supply of common carp on Java Island.
To solve this problem and due to social pressure, the government issued Ministerial Decree no 40 dated 3 October 2002. The degree declared Java and Bali islands as an isolated area of Koi herpes virus (KHV) and specified that the movement of koi and common carp from Java and Bali to other islands should follow a quarantine check for KHV. However, because trucks with live fish often cross the strait without reporting to the checkpoint office, the application of Decree No. 40 has not been effective. Such trucks are usually without documents or certificates of fish health. At Merak, the checkpoint for the movement of live fish from Java into Sumatera Island is not equipped with simple laboratory equipment. Live fish traffic, especially carp, destined to Sumatera, involves around 5–10 trucks per day. The live carp transported to Sumatera originate from KHV-infected areas, i.e. Cirata Reservoir, Sukabumi, Subang, Pandeglang and Jatiluhur. Thus, Merak is a strategic point for the spread of fish disease from Java to Sumatra, since it is the most convenient entry point for inter-island live fish movement between the islands. The spread of KHV disease to the whole of Sumatera through the Merak Check Point is just a matter of time unless there is other policy to stop the infected live fish movement to Sumatera. If Decree No. 40 is to be effective, officers at key checkpoints must be given the necessary infrastructure, authority and manpower to fully enforce regulations (Arthur, 2003). The provincial and district authorities of uninfected regions should be encouraged to regulate the movement of live carp from Java to their regions (Prayitno, 2003). However, the disease spread to Sumatera Island in January 2003 (Yuasa et al., 2004).
Governmental assistance
Besides issuing rules and regulations soon after the outbreak, the government also provided assistance to affected carp farmers. This included new broodstock, disinfectants, diagnostic services, training and consultancies. A website (www.ditkeskanling.go.id) was also established to provide information on the outbreak and fish health management in general. Intensive information dissemination was also undertaken to raise awareness and inform the public sector about KHV and the relevant information available at that time.
Fulfilling international obligations
As a member of the international community, the Government of Indonesia has fulfilled its obligation to report important diseases to the Office International des Épizooties (OIE). A report of the KHV epidemic was sent to OIE on 26 June 2002 (Rukyani, 2002). Since then, a regular report on the KHV outbreak has also been sent to OIE through the NACA/OIE/FAO Asia-Pacific Quarterly Aquatic Animal Disease Reporting System.
NACA's Task Force
In 20 June 2002, Dr. Fatuchri Sukadi, Director General of Aquaculture, Ministry of Marine Affairs and Fisheries, requested assistance for the solution to the outbreak to NACA. NACA's response was to organize the Emergency Disease Control Task Force on a Serious Disease of Koi and Common Carps in Indonesia, subsequently referred to as NACA's “Task Force”, in cooperation with the Australian Centre for International Agricultural Research (ACIAR) and the Aquatic Animal Health Research Institute (AAHRI). The Task Force, which consisted of international and national experts and a number of participating laboratories and organizations, conducted an emergency assessment of the disease situation in July 2002 through field observations (i.e. field visits, interviews with local/district officials and farmers) and laboratory examinations (e.g. histopathology and virology, including use of polymerase chain reaction (PCR), and electron microscopy (EM)) of collected samples).
The Task Force collected vital information about the disease occurrence, epidemiological perspective and provided supportive evidence of a possible KHV infection, the confirmed aetiology of which is yet to be found. The Task Force findings recommended that this serious outbreak of koi and common carp be called “Mass mortality of koi and common carp (MMKC)”until a clear association with KHV or another specific disease can be established. The Task Force also provided several key recommendations for improving the fish health status of Indonesia and reducing possible disease outbreaks (NACA, 2002).
FAO's Technical Cooperation Programme
As follow-up to the recommendations of NACA's Task Force and in response to a request from the Government of Indonesia, FAO immediately provided emergency assistance through a Technical Cooperation Project “Health Management in Freshwater Aquaculture”(TCP/INS/2905(A)), to find resolution to this disease emergency. The project was set up to:
develop and implement Indonesia's National Strategy on Aquatic Animal Health Management.
Under the project, various issues on fish health management in Indonesia were addressed. These included review of policy and legislation, enhancement of the national regulatory framework and development of a national strategy on fish health management. Other related issues on fish health management such as strengthening diagnostic and control capability; improving surveillance, monitoring and disease reporting systems; human resource development and public awareness are being addressed. The project is also concerned with the identification and confirmation of the aetiological agent of the disease and is looking for assistance from international laboratories.
Legislation: The major accomplishments arising from the consultancy on fish health legislation include:
recommendations with regard to future activities.
It should be noted that the short duration of the consultancy, combined with the complicated and extensive nature of the Indonesian legislation on fish health and the complicated structure of the Indonesian fish quarantine service made it impossible to undertake anything more than an initial and incomplete examination of the issues surrounding these sectors. Recommendations are made for more detailed future reviews in these two important areas (Arthur, 2003; Prayitno, 2003).
Fish health management: A consultancy was undertaken to understand the fish health management practices by stakeholders. Below is summary of the findings based on the report of the consultants (Shariff, 2004; Pasaribu, 2004). Investigations revealed that disease outbreaks were a common phenomenon due to the following:
insufficient collaboration among the various institutions for research in fish health.
The major accomplishments arising from the consultancy include:
recommendations with regard to future activities on fish health management.
Epidemiology: The major accomplishments arising from the consultancy are as follows:
recommendations with regards to future activities on research, information system, epidemiology and control of KHV (Cameron, 2003; Rukyani, 2003).
Virology: Equipment, facilities and human resources were reviewed at major laboratories involved in fish health management, and fish disease diagnostics laboratories were visited in order to evaluate current diagnostic capabilities, with particular reference to fish virology. The major accomplishments arising from the consultancy are as follows:
recommendations were made with regard to the future development and activities to sustain the function and operation of the National Virology Unit (Millar, 2003; 2004; Sunarto, 2004).
Surveillance and information system: These issued were addressed mostly by the consultant in epidemiology. The major accomplishments arising from the consultancy are as follows:
construction of a pilot web-based information system on fish health management in Indonesia, with special emphasis on disease reporting system by Dr. Angus Cameron (www.ausvet.com.au/indofish).
A website of the Directorate for Fish Health and Environment (www.ditkeskanling.go.id) was also set up to provide general information on fish health management. Indofish is being placed in the directorate's website.

AGUS SUNARTO
National virology unit of the Fish Health Research Laboratory of Indonesia
Human resource development: Under the project, five training workshops on legislation, epidemiology, virology and fish health management for fisheries officers and key farmers were completed. Four persons attended two-week overseas training at the Aquatic Animal Health Research Institute (AAHRI) in Bangkok, Thailand. The project termination workshop was expanded to an FAO regional workshop conducted on 21–23 September 2004. Dissemination of information regarding fish health management including technical guidelines for KHV and whitespot syndrome virus (WSSV) and a poster for import risk analysis (IRA) were produced and distributed to stakeholders.
HISTORY OF THE OUTBREAK
The history of the outbreak including the first three episodes was chronologically described by Sunarto et al. (2002). The first episode of mass mortalities of cultured koi carp was recorded in March 2002 in Blitar, East Java. It occurred after heavy rains among new fish introduced from Surabaya, the capital city of East Java. The fish were imported from PR China through Hong Kong in December 2001 and January 2002. Blitar is well known as the center for koi production in the country. The koi, including the infected animals, were distributed to the provinces of Central Java, West Java and Jakarta as the main market. The second disease outbreak occurred in cultured common carp during the end of April 2002 in Subang Regency, West Java. The gross signs shown by the diseased fish were extremely similar with that observed previously in koi carp. Subang is one of the production centers of common carp in West Java. Since then the outbreaks spread to neighbouring regencies, mainly through the movement of infected fish. The third episode of the outbreak occurred in the end of May to early June 2002 in cultured common carp in floating netcages at Cirata Reservoir, West Java. Weeks before the outbreak, farmers introduced common carp from the Subang region, due to the low price of these fish.
The fourth episode of the outbreak occurred in January 2003, affecting cultured common carp in Lubuk Lingau Regency, South Sumatera. The gross signs of the diseased common carp were extremely similar to those observed previously in koi and common carp in Java. Mass mortality of more than 90 percent was observed during the outbreak. Common carp farms at Lubuk Lingau were infected with the disease coming from Cirata Reservoir, West Java through fish transfer by traders. In January, the outbreak spread to neighbouring Provinces, including Bengkulu in the south and Jambi in the west (Sunarto, Rukyani and Itami, 2004; Yuasa et al., 2004).
In this paper, two new outbreaks are reported. Although a public awareness campaign conducted by the central and local governments delayed the spread of the disease from southern Sumatera to West Sumatera, in August 2004, an outbreak that killed more than 200 tonnes of cultured common carp occurred in Singkarak Lake and Maninjau Lake, West Sumatera. The gross signs of the diseased fish were extremely similar with those observed previously in koi and carp in Java and southern Sumatera. Common carp farms on West Sumatera were infected with the disease via contaminated seed that is believed to have been transferred from Jambi Province, where KHV disease has occurred since 2003.
The sixth episode of KHV outbreak occurred in carp culture in Banjar Baru, South Kalimantan. The outbreak killed 600 tonnes of common carp in the running water culture system in September 2004. However, the mortality rate was quite low (30–50 percent) as compared with the outbreaks on Java and Sumatera islands. It is speculated that the polyculture of common carp with tilapia and high water temperate (29°C) may reduce mortality rate due to KHV. The spread of KHV into Kalimantan was thought to be due to the irresponsible movement of infected carp broodstock from Malang, East Java, where KHV is endemic.
EPIDEMIOLOGY
The epidemiological investigation was conducted by NACA's Task Force in July 2002. The information presented below is based on the report of Dr. Angus Cameron (Cameron, 2002).

Agus Sunarto
Double cage culture system with first level using common carp and second level using tilapia
Methodology
Investigations were conducted in the east of Java, with visits to Surabaya, Malang and Blitar. The approach used to investigate the disease was as follows:
in conducting the epidemiological investigations, analyzing the findings, and formulating conclusions, the team maintained contact with the laboratory investigation team to assess findings from the west of the island.
Results
The following section presents the results of epidemiological observations gathered during the investigation:
Confirmation of a disease outbreak: The 50–100 percent mortality rates reported by farmers far exceed what is considered normal and therefore a disease outbreak is confirmed.
Pattern of spread of disease: The pattern is typical of a propagating infectious disease, starting in one location and subsequently spreading both locally and over long distances. From each new disease location, further local spread has occurred. The evidence of spread of disease within farms after the introduction of fish is also consistent with the disease being caused by an infectious agent. Disease is spread downstream, with the second case-farm being located about 500 m downstream from the index farm, with a delay of about 20 days between the onset of disease in the two farms. It is still unclear what the main mechanism of water-borne between-farm spread is (whether it is through direct carriage of the virus or through either mechanical or biological vectors). It is suspected that vectors may play a role, as the relatively fragile herpes virus is unlikely to survive for long periods exposed to sunlight in the shallow streams of the region.
Nature of the pathogen: Based on available epidemiological evidence, it can be reported with extreme confidence that the disease is caused by a directly transmitted infectious agent. The rapid transmission of the disease (about seven days between introduction of infected fish and the onset of clinical signs in contact fish) and the observation that transmission has occurred in clean cement tanks with very few potential intermediate hosts present both strongly indicate that the disease is directly transmitted.
Spread of disease: Several mechanisms for spread of disease have been identified. These are:
long distance spread - mainly through fish movements.
Incubation period: The incubation period is about seven days, and the contact rate is very high, allowing a large number of fish to become infected from a single shedding fish.
Cause of the current outbreak: There are a number of pieces of evidence that strongly suggest that the cause is viral, and is most likely to be KHV. The host specificity and pattern of mortality is the same as that described for KHV (Hedrick et al., 2000) in earlier outbreaks (analogy). The observation in one experiment that the disease recurred in recovered fish once they were stressed is typical of latent herpes virus behaviour, and unlikely in any of the other pathogens under consideration (experimental). The failure of response to treatment with antibiotics reported in a number of cases probably provides a weak evidence that the cause may not be bacterial (response to treatment). The finding of positive PCR results from affected fish (and the negative finding from unaffected fish) confirms these epidemiological assessments.
Risk factors: A number of risk factors may play a role in disease development, based on direct field observations and anecdotal evidence. These include the following:
water quality, management factors, feed and treatments.
GEOGRAPHICAL DISTRIBUTION
A survey of KHV was conducted in April 2003 under FAO's Technical Cooperation Programme. The information presented below is based on the reports of Dr. Angus Cameron and Dr. Akhmad Rukyani (Cameron, 2003; Rukyani, 2003).
Objective
The main objectives of the survey were to determine the extent and the distribution of the population at risk against KHV, the current distribution of the disease and extent of the disease.
Methods
In order to achieve these objectives and meet the criteria listed above, a rapid survey at the district (kabupaten) level as a unit of interest was conducted. The survey was conducted in all of the country's 353 districts. A printed questionnaire was used to collect data. The questionnaire was pre-printed with the name of each district and province, as well as the district code, to simplify the data entry. The questionnaire was designed to be as simple and as rapid as possible to be completed, consisting of only seven questions. These related to:
an estimate of the number of farms affected by KHV.
The questionnaire was delivered by mail to each district office. It was accompanied by an official covering letter explaining the survey and giving instructions on how to fill out the questionnaire, and an information sheet on KHV (with case definition) to enable district fisheries staff that were not familiar with the disease to determine if outbreaks in their area met the case definition.
Results
This survey is the first epidemiological survey that has been conducted in the field of fish health in Indonesia. The survey was very successful, not only in terms of the high response (90 percent of questionnaires returned), but also in terms of developing better communication and networking between the central and district levels.
Population at risk: Based on the survey results, the distribution of the population at risk (i.e. koi and common carp) is shown on the map given in Figure 1.
Progression and geographic distribution of the disease: There are arguments among scientists on when the first KHV outbreak occurred in Indonesia. This survey was designed to address this issue. The results show that the outbreak first occurred at Blitar, East Java in March 2003 and then spread to Subang, West Java (Figure 2.). The geographic distribution of KHV in Indonesia as of February 2003 is illustrated in Figure 3. The red colour indicates the districts affected by disease.
SURVEY CONCLUSIONS
This is the first epidemiological survey that has been conducted in the field of fish health in Indonesia. The communication established during the survey should lead to better communication and cooperation among institutions in the central and district level in the future. Networking with key districts should be maintained and further developed through regular communication and sharing of information on fish health matters. Finally, 90 percent (315 out of 353) of the survey questionnaires were returned. From the survey, it was found that the disease has infected most of Java, Bali, Lampung, Bengkulu and South Sumatra, as well as making incursions into Kalimantan and Sulawesi. Nationally, 31 percent of the districts culturing susceptible species (common and koi carps) reported the presence of KHV.
Patterns of local and long-distance spread were further assessed by a district (kabupaten) level national survey. The survey found that there was gradual local spread from numerous foci of infection, as well as occasional long-distance spread, initially within Java, but also to other islands. It is hypothesised that the long-distance spread is mainly associated with the transport of the high-value ornamental koi carp, while local spread is through water and local transport of common carp for human consumption.
CLINICAL ASPECTS
Infected fish were lethargic, showed loss of balance and gasped for air. Some dead fish had sloughing off the epithelium with loss of mucus and rough appearance of the skin, darkened skin or showed blister-like lesions on the skin and haemorrhages of the operculae, fins and abdomen. However, the most common clinical sign was gill damage seen as whitish coloration, white patches or severe necrosis (Figure 4).
FIGURE 1
Map showiing the distribution of common (red) and koi
(blue) carp production areas in Indonesia. Pale grey areas indicate no data,
dark grey indicates no production (source: Cameron, 2003; Rukyani, 2003).

FIGURE 2
Map of the KHV outbreak during its first occurrence at Blitar (koi) and Subang (common carp) in March 2002. Pale grey
areas indicate no data, green areas indicate no reported KHV, red areas have
reported KHV in either common or koi carp (source: Cameron, 2003; Rukyani,
2003)

FIGURE 3
Map showing the geographic distribution of reported KHV in
Indonesia as of February 2003. Pale grey areas indicate no data, green areas
indicate no reported KHV, red areas have reported KHV in either common or koi
carp (source: Cameron, 2003; Rukyani, 2003)

FIGURE 4
Diseased fish showing typical clinical signs - gill damage
such as whitish gills (A) and severe gill necrosis (B). Some fish also showed blister-like lesions on the skin and
white patches on the gills (C).

SPECIES AFFECTED
Although the disease was observed as being highly contagious and extremely virulent, morbidity and mortality were restricted to koi and common carp populations. Several other species stocked within the same ponds remained completely asymptomatic to the disease. Co-culture with a number of other species was observed in Blitar (with tilapia and gouramy) and in Cirata Reservoir (which utilizes a double cage system using carp and tilapia), and in all cases only carp were affected by the disease. However, it is not known yet whether the fish harbour the virus and act as carriers. Screening of other cultured and wild fishes such as tilapia, giant gouramy, catfish and Siam catfish, collected from the same cage, pond or canal of surrounding farms showed PCR negative results against KHV. The fish were tested with single step PCR using the primer set developed by Gray et al. (2002) and Gilad et al. (2002). However, further screening of the fish using double step PCR will confirm whether the fish is harboring the virus or not.
SOCIO-ECONOMIC IMPACT
The first report regarding the economic losses due to the outbreak was made by the head of the Association of Ornamental Fish Culture of Blitar Regency, East Java. They reported that in Blitar alone, the outbreak destroyed high quality koi carp belonging to 5000 fish farmers with economic losses of more than Rp. 5 billion (US$0.5 million) within the first three months of the outbreak. As of July 2002, the Task Force estimated that the loss of revenue to the sector and the socio-economic impact to the rural farming communities were in the region of US$5 million. As the outbreaks continued and the disease spread to new areas, the socio-economic impact escalated. The Directorate of Fish Health and Environment (DFHE) estimated that as of December 2002 and 2003, losses due to KHV were US$ 10 million and US$15 million, respectively (Sunarto et al., 2004).
PUBLIC HEALTH
There has been a great deal of local apprehension as to the consequences of consuming diseased fish. This is particularly affected by the fact that the some of the diseased fish showed blister-like lesions (Figure 4) and the word “herpes”, which is associated with herpes virus in humans. There is however, no scientific evidence that the disease causes any human illness. In some outbreaks, large volumes of affected fish were sold or given away to people living in the local area for consumption, and there have so far been no reports of ill effects as a result of this. The government has conducted campaigns to eat carp. Fortunately, the Indonesian community has the habit of eating cooked fish, either fried or steamed.
AETIOLOGY
Screening for parasites, fungi and bacteria showed multiple infections on affected fish. Dactylogyrus sp., Trichodina sp., Ichthyophthyrius multifiliis and Argulus sp. were found on some debilitated fish. Flexibacter columnaris and Aeromonas hydrophila were isolated from necrotic gill filaments and skin ulcers of affected fish, respectively. Saprolegnia sp. and Achyla sp. were found in some fish showing blister-like lesions. All these species are suspected to be endemic in Indonesia and can be found in unaffected fish, so are unlikely to play a central role in the development of the disease. Attempts have been made to treat the infected fish with potassium permanganate and antibiotics (enrofloxacin, erythromycin, amoxicylin and oxytetracycline), but with no success.
At the beginning of these outbreaks, many causative factors were proposed, including water pollution, contaminated feed and bacterial infection. An infectivity trial was then conducted to elucidate the causative agent of the outbreak. Cohabitation of diseased fish with healthy common carp resulted in 100 percent mortality within an 8-day period. Experimental infections with 0.45 m-filtered homogenates resulted in 70 percent mortality during a 14-day period. Similar clinical signs (i.e. gill necrosis) were observed in both groups in the cohabitation test and injection of filtrate homogenate test.
PCR detection of KHV naturally diseased fish showed that some affected common carp produced a single band 290 base pair (bp) (Gray et al., 2002) or 484 bp (Gilad et al., 2003) in size, that would be expected if KHV DNA was present. However, other common carp collected from the same pond gave negative results. Partial DNA sequencing of the 484 bp amplicon revealed that the DNA sequence of KHV from Indonesia has high similarity (99.65 percent) with the DNA sequence of KHV from the United States. Nucleotide sequences of the three regions (KHV9/5 primer set amplicon, SphI-5 primer set amplicon, and thymidine kinase) of KHV DNA from Indonesia, Japan and Taiwan were identical (Ito et al., 2004).
Virus isolation was attempted onto the KF-1 cell line, the cell line most appropriate for the isolation of KHV, as well as onto GP, EPC, BB, BF-2, DT and SSN-1, but did not result in any observable cytopathic effects (CPE). However, these negative results may be caused by inappropriate sample preparation. The samples were collected in various infected farms, brought to the laboratory and processed prior sending to Intervet Singapore, AAHRI (Thailand) and the University of California at Davis (United States). These extracts had arrived in the laboratories after several days of shipping and no refrigeration. Thus, it would not be surprising that no viral agents could be isolated.
However, based on the history, clinical signs, epidemiological features, histopathological changes, results of experimental infection, PCR detection of naturally and experimentally diseased fish, and analysis of DNA sequence, it is confirmed that KHV involved in this serious outbreak.
ENVIRONMENTAL FACTORS
Most of the outbreaks occurred when infected fish were introduced to non-infected fish, farms or areas. The heavy rain prior to the initial outbreak indicated the possibility of an environmental triggering factor, such as water temperature. Another environmental factor that may trigger outbreaks is stress caused by, for example, high stocking density and low water quality. However, research is needed to elucidate the environmental and other factors that trigger outbreaks.
DIAGNOSTIC METHODS
Appropriate diagnosis of KHV is important to avoid confusion with other diseases in carp. The haemorrhage and blister-like lesions seen in diseased fish may lead to a misdiagnosis as Aeromonas hydrophila infection. Flexibacter columnaris also causes gill necrosis. In fact these two bacteria were also found in the infected carp during the episode of mass mortality. Therefore, a case definition was established as an important step in the disease investigation in order to determine whether or not an individual fish, pond or tank is suffering from the disease. The case definition was used to minimize misdiagnosis. In the case of KHV, the case definition used was high mortality in koi or common carp, in which the fish shows gill damage, with or without other clinical signs.
Clinical signs and gross pathology
Infected fish were lethargic, showed loss of balance and gasped for air. Common gross signs included sloughing off the epithelium with loss of mucus and a rough appearance of the skin, haemorrhages of operculae, fins and abdomen, and severe gill damage. Some diseased fish showed a blister-like lesion on the skin, so called “penyakit melepuh”in the Indonesian language. As the outbreak continued, various clinical signs were observed or reported; however, the only consistent clinical sign was severe gill necrosis. Therefore, this pathognomonic clinical sign was used to establish a presumptive diagnosis against KHV (diagnosis level 1).
Histopathology
Although histopathological changes due to KHV were not obvious in most of the diseased fish, some diseased fish showed consistent findings with various lesions. Acute dermatitis with bacterial colonies occurred on the skin. Branchitis and numerous parasites including protozoans and metazoans, and bacterial colonies were present on the gills. Occasionally, intranuclear amphophilic inclusion bodies with peripheral chromatin margination were observed within the gill's epithelium. Similar inclusions were also observed within the kidney tubular epithelium accompanied by nephrocalcinosis. The interrenal extramedullary hematopoetic tissue showed haemorrhage or haemosiderosis. Epicarditis, myocarditis and endocarditis were demonstrated in the heart. Multifoci of chronic pancreatitis with acinar cell necrosis were present in the pancreas. The liver displayed various types of degeneration such as hydrophic degeneration and fatty change. Occasionally, vasculitis and bile stases were observed within the sinusoid of the liver. The spleen was congested and displayed the occurrence of perivascular amyloidosis (diagnosis level 2).
PCR detection
PCR detection of KHV was carried out using specific primers set developed by Gray et al. (2002) and Gilad et al. (2002). Nine laboratories in Sumatera, Java and Sulawesi have routinely used PCR assay for confirmative diagnosis against KHV (diagnosis level 3). However, mixed results were occasionally found by using this molecular-based method. As the detection of fish pathogens in Indonesia using PCR assay is still in its early development, standardized methods and harmonization of PCR application is urgently needed to ensure high quality results.
CONTROL MEASURES
The recent increase in live-fish traffic is increasing the risk of introduction and spread of fish pathogens throughout the country. Past and recent disease outbreaks among cultured and wild fish have prompted the government to carry out a programme to control disease and protect fishery resources.
Attempts to control the outbreak at the farm level have also been made. These efforts include curative approach (treatment by using of antibiotics, disinfectants and other pharmaceuticals) and a preventive approach (by quarantine measures, biosecurity, vaccination and good management practices (GMPs)).
Treatment
No drugs or other pharmaceuticals have been found to be effective in combating the disease. Attempts have been made to treat the infected fish with antibiotics, but without success. Some fish farmers have tried to use potassium permanganate (PK) for treatment. However, PK tends to irritate the gills, leading to a surging mortality up to 80–95 percent of affected fish. Since other pathogens such as parasites, fungi and bacteria were also found in the diseased fish, antibiotics and disinfectants were used to treat these secondary infections. Enrofloxacine (5–10 ppm) was used to treat secondary bacterial infection. Dyvon (dichlorphos) at 1–5 ppm and benzalkonium chloride (BKC) at one drop/100 L were used to treat Argulus and other parasitic infections.
Quarantine
Since most outbreaks occur after the introduction of new infected fish, it is obvious that the disease is spread by direct contact. Therefore, the effective way to protect a non-infected area from being infected with the disease is by preventing the introduction of infected fish. It is recommended that all new fish be quarantined for at least two weeks, together with sentinel fish at a permissive water temperature between 18–28 °C.
Biosecurity
Most outbreaks occurred after the introduction of new fish from an infected area or through infection via contaminated equipment or water source. Therefore, the biosecurity concept may be applied to prevent or reduce the possibility of KHV infection. For areas where KHV is presently endemic, a prevention programme should include eradication and exclusion activities. Given that KHV also occurs in wild carp stocks, it can be difficult to control outbreaks in common waterbodies such as in floating netcages in lakes and in raceways in rivers. Although little is known about how the virus survives between the outbreaks, available evidence suggested that infections may persist in the susceptible fish population remaining at the site between crops. Accordingly, measures to eradicate the virus should include: removal of all fish (particularly all susceptible fish species) from ponds, reservoirs, and water canals prior to restocking, drying out and liming the ponds and disinfecting of contaminated equipment. Potassium permanganate (10 ppm), chlorine (200 ppm) and formalin (500–1000 ppm) were commonly used as disinfectants. Once the virus has been eradicated from a site, it is important to prevent re-introduction. It is likely that infection is spread by affected fish, as well as by contaminated water and equipment. Ronen et al. (2003) reported that KHV remains active in the water for at least four hours. Accordingly, the following measures should be considered for the exclusion of the virus from fish farms: seed and broodstock should be KHV-free or be obtained from KHV-free areas, all wild carps must be rigorously excluded from farms in endemic areas, use only KHV-free water, either decontaminated or originating from KHV-free water sources, and equipment which may have been used at infected sites must be disinfected. These practices have been adopted and proved to be effective to prevent the outbreak in an isolated koi farm. However, they may not applicable for culture systems in open waters such as cage culture in lakes and raceway culture in rivers. In these systems, GMPs may be applied to reduce mass mortality due to KHV infection.
Good management practices
KHV now appears to be endemic in most areas of Indonesia where carp and koi are cultured including Java, Bali, Sumatera and Kalimantan. Emphasis should now be placed on learning how to manage the disease so that carp production in infected areas can be maintained (Arthur, 2003). There are scattered reports from fish farmers that GMPs can reduce the incidence of and mortality due to KHV infection in koi and carp culture. However, these reports need to be backed up with scientific data. The koi farmer association of Blitar Regency reported that although KHV is still found in their koi, the mortality due to KHV is very low. There is an area in Cirata Reservoir that managed to get free from the outbreak, even though sharing the same waterbody with other infected areas. Blitar and Cirata are the centers of production of koi and common carp, respectively. These two areas were badly affected by the outbreak in 2002. There are reports that transferring diseased fish from raceways to earthen ponds will decrease mortality and prevent further losses. It seems that this practice reduces the stocking density and provides stable water temperature, hence providing a better environment for the fish. Other farmers have reported that polyculture of common carp with other fish species such as tilapia and gouramy, also reduces the severity and frequency of KHV outbreak.
It is important that the general health, as well as the KHV status, of a susceptible fish population is monitored regularly during the grow-out period. High doses of vitamin C (500 mg/kg feed) were used to enhance fish immunity against infection. It is hypothesized that the disease outbreaks do not occur if the fish's defence mechanisms manage to contain low-intensity of KHV infection under low-stress culture conditions. Conversely, outbreaks may occur under stressful conditions. Therefore, avoiding stress factors such as high stocking density, fluctuating water temperature, low dissolved oxygen and improper handling of fish are essential to reduce the risk of outbreak. It is recommended to remove dead and moribund fish from the pond, as they are a good reservoir for the virus. Record keeping, epidemiological analysis and accurate diagnostic tools are essential for pond monitoring. To break the life cycle of KHV and to avoid re-occurrence of outbreaks in endemic areas, it is recommended to farm species that are resistant to KHV, such as tilapia, gouramy and catfish.
Vaccination
Attempts have been made to control outbreaks by using antibiotics and other drugs, but this has had no success. As KHV is an immunogenic virus, preventive measures a using vaccination programme would be effective to control the disease (Ronen et al., 2003). A preliminary “vaccination trial”by temperature manipulation has been conducted in the Fish Health Research Laboratory (Gardenia et al., 2004). The trial methods involved the cohabitation of healthy fish with sick fish at permissive temperature (26–28 °C) and their subsequent transfer to non-permissive temperature (32–35 °C). At thirty days post-exposure, the vaccinated fish were then challenged by cohabitation with sick fish. The results show that the vaccinated group has lower mortality (33 percent) compared with the control group (86 percent). Although beneficial to reduce the mortality of fish, this vaccination method involves a serious risk due to the use of live virus. Research on the development of inactivated vaccine is being conducted.
CONCLUSIONS
The NACA's Task Force findings revealed that an infectious agent is involved in the current outbreak. Epidemiological evidence and positive PCR findings from 82.5 percent (33/40) of the case samples indicated that the outbreak was most probably caused by KHV, despite the failure to isolate the virus, to observe the virus with electron microscopy and to find typical histopathological changes described in other cases of KHV. The disease was introduced into Indonesia through fish importation and spread to other areas within the country through fish movements. Since most of the episodes of mass mortality in koi and common carp occurred within a few weeks after the introduction of infected fish into disease-free areas, the responsible movement of live fish and quarantine of incoming fish seem to be a logical way to prevent the introduction and spread of the disease to new areas.
Although KHV is strongly suspected to be the cause of the outbreak, this has yet to be confirmed. Further research on the identification and confirmation of the disease is urgently needed. Other areas of research that need to be pursued include the development of standardized procedures for the detection of the virus, with emphasis on the detection of subclinical fish and potential carriers, if any. Research is also needed to identify environmental and predisposing factors and to analyze risk factors that trigger the outbreaks. Control strategy through the development of vaccines is another area of research that should be considered.
Despite the difficulties in the control of outbreaks in common waterbodies such as raceway culture in rivers and netcages in reservoirs and lakes, a vaccination programme, biosecurity measures and GMPs seem to provide alternative control strategies at the farm level. However, further research is needed to analyse the cost effectiveness of a vaccination programme in common carp and to identify the key components of biosecurity and GMPs that are effective to control KHV outbreaks. Although, the government has attempted to restrict the spread of the disease to new areas by issuing rules, regulations and technical guidelines, the disease is still spreading to new areas. Better law enforcement and improved public awareness are essential to ensure the proper implementation of the regulations and guidelines.
The Government of Indonesia still faces significant challenges in the implementation of emergency response to disease outbreak. Capacity building on emergency preparedness and response is needed to properly manage disease emergencies. The general approach would be the proper development and implementation of the National Strategy for Fish Health Management.
ACKNOWLEDGEMENTS
The authors wishes to thank NACA Task Force members Dr Somkiat Kanchanakhan and Dr Melba Bondad-Reantaso and FAO's national and international consultants Prof Mohamed Shariff, Dr Richard Arthur Mr Stuart Millar, Prof S.B. Prayitno, Dr Fachriyan H. Pasaribu and the late Dr Akhmad Rukyani for sharing their reports and findings before publication.
LITERATURE CITED
Arthur, J.R. 2003. Fish health management for Indonesia. Report of international consultant on legislation. Project TCP/INS/2905(A). Health Management in Freshwater Aquaculture 55 pp. FAO, Rome.
Cameron, A. 2002. Report of an epidemiological investigation of a serious outbreak of disease amongst koi and common carp in Indonesia. Report prepared for the Emergency Disease Control Task Force on a Serious Disease of Koi and Common Carps in Indonesia. 72 pp. NACA, Bangkok.
Cameron, A. 2003. Report of international consultant in epidemiology. Project TCP/INS/2905(A). Health Management in Freshwater Aquaculture 62 pp. FAO, Rome.
Crane, M., Sano, M. & Komar, C. 2004. Infection with koi herpesvirus - disease card. In: NACA/FAO. Quarterly aquatic animal disease report (Asia and Pacific Region). April–June 2004, 2004/2. pp. 43–47. Bangkok, NACA.
Gardenia, L., Sunarto, A., Koesharyani, I., Taukhid & Novita, H. 2004. Immunogenic potency of koi herpesvirus in common carp. Technical Report submitted to the Research Institute for Freshwater Fisheries. Bogor. 12 pp. (in Bahasa Indonesia)
Gilad, O., Yun, S., Adkison, M.A., Way, K., Willits, N.H., Bercovier, H. & Hedrick, R.P. 2003. Molecular comparison of isolates of an emerging fish pathogen, koi herpesvirus, and the effect of water temperature on mortality of experimentally infected koi. J. Gen. Virol., 84: 2661–2668.
Gray, W.L., Mullis, L., LaPatra, S.E., Groff, J.M. & Goodwin, A. 2002. Detection of koi herpesvirus DNA in tissue of infected fish. J. Fish Dis., 25: 171–178.
Hedrick, R.P., Gilad, O., Yun, S., Spangenberg, J.V., Marty, G.D., Nordhausen, R.W., Kebus, M.J., Bercovier, H. & Eldar, A. 2000.A herpesvirus associated with mass mortality of juvenile and adult koi, a strain of common carp. J. Aquat. Anim. Health, 12:44–57.
Ito, T., Kurita, J., Miwa S., Yuasa, K., Hedrick, R.P., Engelsma, M., Haene, O., Chou, H.Y., Tung, M.C., Sunarto, A., Sano M. & Iida, T. 2004. Outbreak of the koi herpesvirus infection in Japan. Book of Abstracts, the 7th Asian Fisheries Forum, Penang, Malaysia, 30 November – 4 December 2004. p. 409.
Millar, S.D. 2003. Report of international consultant in virology: first mission. Project TCP/INS/2905(A). Health Management in Freshwater Aquaculture. 44 pp.FAO, Rome.
Millar, S.D. 2004. Report of international consultant in virology: second mission. Project TCP/INS/2905(A). Health Management in Freshwater Aquaculture. 45 pp. FAO, Rome.
NACA. 2002. Report of Emergency disease control task force on a serious disease of koi and common carps in Indonesia. 24 pp.NACA, Bangkok.
Pasaribu, F.H. 2004. Report of national consultant in fish health management. Project TCP/INS/2905(A). Health Management in Freshwater Aquaculture. 38 pp. FAO, Rome.
Prayitno, S.B. 2003. Legislation on fish health management: report of national consultant in legislation. TCP/INS/2905(A). Health Management in Freshwater Aquaculture. 38 pp. FAO, Rome.
Ronen, A., Perelberg, A., Abramowitz, J., Hutoran, M., Tinman, S., Bejerano, I., Steinitz, M. & Kotler, M. 2003. Efficient vaccine against the virus causing a lethal disease in cultured Cyprinus carpio. Vaccine, 21: 4677–4684.
Rukyani, A. 2002. Koi herpesvirus in Indonesia: suspicion. Report of KHV epidemic to OIE (available at www.oie.int).
Rukyani, A. 2003. Report of national consultant in epidemiology. Project TCP/INS/2905(A). Health Management in Freshwater Aquaculture. 54 pp. FAO, Rome.
Shariff, M. 2004. Fish health management for Indonesia: report of international consultant in fish health management. Project TCP/INS/2905(A). Health Management in Freshwater Aquaculture. 47 pp. FAO, Rome.
Sunarto, A. 2004. Report of national consultant in virology. Project TCP/INS/2905(A). Health Management in Freshwater Aquaculture 72 pp. FAO, Rome.
Sunarto, A., Rukyani, A., Cameron, A., Bondad-Reantaso, M. & Subasinghe, R. 2004. Outbreak of disease causing mass mortality in koi and common carp (Cyprinus carpio) in Indonesia. Book of Abstracts, the International Workshop on Koi Herpesvirus, London, England, 12–13 February 2004. p. 12.
Sunarto, A., Rukyani A. & Itami, T. 2004. Indonesian experience on the outbreak of koi herpesvirus in koi and carp (Cyprinus carpio). Bull. Japan Fish. Res. Agency, Supp. 2: 12–19. (in press)
Sunarto, A., Taukhid, Rukyani, A., Koesharyani, I., Supriyadi, H., Gardenia, L., Huminto, H., Agungpriyono, D.R., Pasaribu, F.H., Widodo, Herdikiawan, D., Rukmono, D. & Prayitno, S.B. 2002. Field investigations on a serious disease outbreak among koi and common carp (Cyprinus carpio) in Indonesia. Diseases in Asian Aquaculture V. (in press).
Yuasa, K., Panigoro, N., Bahnan, M., Kholidin, E.B., Koesharyani, I. & Hatai, K. 2004. Outbreak of KHV infection in common carp in Sumatera, Indonesia. Book of Abstracts, 7th Asian Fisheries Forum, 30 November – 4 December 2004, Penang, Malaysia. p. 133.
Takaji Iida, Motohiko Sano, Takafumi Ito, Jun Kurita, Kei Yuasa
and Satoshi Miwa
Aquatic Animal Health Division
National Research Institute of Aquaculture (NRIA)
Fisheries Research Agency
Nansei, Mie 516-0193, Japan
Iida, T., Sano, M., Ito, T., Kurita, J., Yuasa, K. & Miwa, S. 2005. Responses to Koi herpes virus (KHV) outbreaks in Japan. 107–111. In: Subasinghe, R.P.; Arthur, J.R. (eds.). Regional workshop on preparedness and response to aquatic animal health emergencies in Asia. Jakarta, Indonesia, 21–23 September 2004. FAO Fisheries Proceedings. No. 4. Rome, FAO. 2005. 178p.
ABSTRACT
The mass mortality among common carp (Cyprinus carpio) caused by Koi herpes virus (KHV) infection occurred in early October 2003 in Japan. KHV infection has been diagnosed in accordance with a guideline for the disease, and confirmation is based on the results of the polymerase cahin reaction (PCR) examinations. The local authorities have officially declared that the movement of KHV-affected common carp and koi is prohibited and have ordered the destruction of KHV-affected common carp and koi under the Law to Ensure Sustainable Aquaculture Production.
INTRODUCTION
Koi herpes virus (KHV) is highly contagious and virulent in common carp and koi (Cyprinus carpio). KHV infection first occurred in 2003 in Japan, and has caused heavy damage to common carp culture. In this report, we present responses to the KHV outbreak and the current status of the disease in Japan.
DIAGNOSTIC SYSTEM FOR EXOTIC DISEASES AND KOI HERPES VIRUS DISEASE
In Japan, some exotic diseases are designated as “Specific Diseases”in the Law to Ensure Sustainable Aquaculture Production (Law No. 51, 1999). This designation is used for exotic diseases such as spring viraemia of carp (SVC) and viral haemorrhagic septicemia (VHS) of salmonid fish that have the potential to devastate the aquaculture industry in Japan. For such diseases, protective guidelines are established. The guidelines provide etiological information, diagnostic procedures, and description of the clinical signs and other important characteristics of the disease. Laboratory diagnoses of the diseases should be conducted in accordance with these guidelines.
A newly isolated herpes virus, Koi herpes virus (KHV), was first reported as a pathogen causing of mass mortality of common and ornamental (koi) carp cultured in Israel and the United States in 1998 (Hedrick et al., 2000). In Japan, no such mass mortality of cultured carp had been reported, and KHV had not been detected by a survey conducted in Niigata Prefecture (Amita et al., 2002). It has been shown that KHV is highly contagious and virulent in juvenile and adult carp (Hedrick et al., 2000, Perelberg et al., 2003). Therefore, on 30 June 2003 KHV infection was added to “Specific Diseases”in the Law, and an inspection chart was established in the guidelines (Fig. 1).
FIGURE 1
Inspection chart for KHV infection according to the Japanese guidelines

According to the chart, the Prefectural Fisheries Experimental Stations first conduct epizootic and routine clinical examination on diseased fish. The most important epizootilogical aspects of KHV disease are that it only affects common and koi carp (C. carpio) and it occurs, remarkably, at temperatures from 18 to 28 °C (Hedrick et al., 2000; Gilad et al., 2003). Therefore, the water temperature and affected species of fish should be determined during a field examination. Few external signs are usually visible, but pale and necrotic gills are frequently evident. Infections by Flavobacterium columnare (=Flexibacter columnaris) and some protozoan parasites such as Chilodonella and Trichodina are sometimes found on necrotic gill lesions, easily leading to misdiagnoses.
If any doubt remains as to the presence of KHV infection, a polymerase chain reaction (PCR) test can be used to detect KHV DNA in the tissues of fish, usually gills. The PCR method described by Gray et al. (2002) was adopted in the inspection chart as the primary examination to be conducted by the Prefectural Fisheries Experimental Stations. When there is some evidence of a positive reaction in the PCR test for KHV, the sample is sent to the National Research Institute of Aquaculture (NRIA) for further examination by the PCR methods of both Gilad et al. (2002) and Gray et al. (2002) for confirmation. Viral isolation is also attempted using KF-1 cell line (Hedrick et al., 2000). Because of the difficulty of isolating the virus in the cell line, the results of the isolation trial are considered supplementary data. Confirmation is based on the results of the PCR examinations.
OCCURRENCE OF KHV INFECTION IN JAPAN AND PRACTICAL DIAGNOSIS OF THE DISEASE
The mass mortality among common carp cultured in net-pens at Lake Kasumigaura, Ibaraki Prefecture, central Japan, began in early October 2003 (Fig. 2). At the time, the water temperature of the lake was 16–18 °C. The fish swam lethargically near the water surface. No marked external signs were observed in the most affected fish, but a whitish mucous-like substance on the body surface, redness of the fins and body, fin rot, and discoloration of the gills with some necrosis were sometimes noticed. The mortality was over 60 percent in the most severe cases, especially in larger carp (those in older than 2-years-old). The losses of the cultured carp were estimated to be 660 metric tonnes in early November and reached approximately 1200 tonnes by mid-November, which is approximately one quarter of the annual production of the lake.
FIGURE 2
Mass mortality of common carp caused by KHV at Lake Kasumigaura

External parasites, such as Chilodonella, Trichodina and Gyrodactylus, were sometimes seen on the necrotic gill tissues of the affected fish. Marked histopathological changes were observed in the gill of the diseased carp (Fig. 3). The secondary lamellae were often fused with hyperplastic branchial epithelium where cell necrosis or the infiltration of lymphocytes was often observed. Congestion and hemorrhage were sometimes observed. In some cases, the branchial tissues were severely degraded and numerous bacteria were seen in the lesions. These histopathological changes are similar to those seen in the previous reports of KHV infection (Hedrick et al., 2000; Tu et al., 2004). Unlike with the previous report of Hedrick et al. (2000), nuclear changes characterized by hypertrophy and margination of chromatin were rarely observed. No bacteria dominantly isolated from the kidney of affected fish were observed on trypticase soy agar (TSA). The PCR for KHV amplified specific bands by the methods of Gray et al. (2002) and Gilad et al. (2002) (Fig. 4). Direct sequence of the amplicon by the primer set of Gray et al. (2002) corresponded completely with the GenBank accession no. AY568951, and that by the primer set of Gilad et al. (2002) showed 99 percent matching to AF411803.
FIGURE 3
A tissue section of the gill from affected common carp
cultured at Lake Kasumigaura. Arrowheads indicate secondary lamellae. H&E stain

FIGURE 4
Gel electrophoresis of the products (292bp) amplified with the primer set sph I-5
of Gray et al. (2002) from the extracted
sample of gill and kidney of affected fish cultured in Lake Kasumigaura. Pc:
positive control, Nc: negative control. 1 percent agarose gel stained with
ethidium bromide

Properly, on 2 November 2003, the Ministry of Agriculture, Forestry and Fisheries of Japan officially announced the first occurrence of the disease in Japan.It was also reported to the Office International des Épizooties (OIE). According to the Law, the Governor of Ibaraki Prefecture officially prohibited the movement of cultured carp from the lake, and ultimately ordered that all carp cultured in the lake were to be destroyed by the end of March 2004.
OTHER EVIDENCE OF KHV BEFORE THE OUTBREAK AT LAKE KASUMIGAURA
Independently of the KHV outbreak at Lake Kasumigaura, a massive loss in excess of 10000 carp occurred in the rivers and a lake in Okayama Prefecture, western part of Japan, in late May to mid-July 2003. In November 2003, the NRIA detected KHV DNA by PCR in the samples of the diseased fish stored in a freezer. This demonstrates that KHV had been introduced into Japan by May before the Lake Kasumigaura outbreak.
THE SPREAD OF KHV IN JAPAN
The KHV-infected common carp cultured in Lake Kasumigaura had been transferred to other areas in Japan before the first detection of the KHV DNA by PCR, and therefore, the virus had spread as a result. In warm-water facilities such as those used for indoor game fishing, some mortality of carp was recorded. However, in many cases KHV was detected in carp with no mortality; this was attributed to the fact that the water temperature was gradually decreasing at the time. By the end of 2003, the NRIA has accepted 529 individuals of 87 cases to be diagnosed, and KHV-infected carp were found in 23 out of 47 prefectures in Japan.
No occurrence of the disease was reported during the winter period. However, as the water temperature increased in the spring of 2004, KHV reappeared in the area where the disease had been recorded and also in new places. In many of the facilities that experienced outbreaks of KHV infection during the previous season, the disease has not been observed so far this year. In these places, all the carp, as well as other fish species, were removed and the facilities were properly treated with disinfectants after the outbreaks. By the end of July 2004, KHV infections have been reported in 39 prefectures in Japan.
OFFICIAL CONTROL MEASURES IN JAPAN
The Government of Japan has conducted surveillance throughout the country and has controlled the movement of common and koi carp through local governments in accordance with the advice issued by the Technical Commission for KHV Disease. The commission is comprised of experts in fish pathology and representatives from the Prefectural Fisheries Experimental Stations.
Each local government has inspected common and koi carp within its territory for signs of infection and has checked for the presence or absence of KHV infection using a PCR test. The local authorities of the KHV-affected area have officially declared that the movement of common carp and koi carp from the area where KHV has been confirmed to other areas is prohibited and have ordered the destruction of common and koi carp in the area under the Law.
RESEARCH ACTIVITIES ON KHV AT NRIA
The NRIA and other research groups, including universities and the Southeast Asian Fisheries Development Center (SEAFDEC) have begun a research project on KHV infection funded by the Ministry of Agriculture, Forestry and Fisheries of Japan. This project, which will have a duration of three years, consists of three major activities: 1) molecular virology and histopathology of KHV infection, including viral behavior in infected fish at different temperatures and a carrier state; 2) development and evaluation of diagnostic tools such as a loop-mediated isothermal amplification (LAMP) method and immunocytochemistry; and 3) measures to control infection, including the efficacy of disinfectants, vaccination and elevation of the rearing water temperature. The results could contribute for controlling KHV infections in both wild and cultured populations of carp.
ACKNOWLEDGEMENTS
We are grateful to Prof. Ronald P. Hedrick of the University of California, Davis, the United States, for his invaluable suggestions and for providing the KF-1 cell line and a KHV isolate. We thank the Ibaraki Prefectural Experimental Station and Okayama Prefectural Experimental Station for providing the sample fish, and the staff of the Aquatic Animal Health Division, National Research Institute of Aquaculture for running diagnoses of KHV infection.
LITERATURE CITED
Amita K., Oe, M., Matoyama, H., Yamaguchi, N. & Fukuda, H. 2002. A survey of Koi herpes virus and carp edema virus in colorcarp cultured in Niigata Prefecture, Japan. Fish Pathol., 37: 197–198.
Gilad O., Yun, S., Andree, K.B., Adkison, M.A., Way, K., Willits, N.H., Bercovier, H. & Hedrick, R.P. 2003. Molecular comparison of isolates of an emerging fish pathogen, Koi herpes virus, and the effect of water temperature on mortality of experimentally infected koi. J. Gen. Virol., 84: 2661–2668.
Gilad O., Yun, S., Andree, K.B., Adkison, M.A., Zlotkin, A., Bercovier, H., Eldar, A. & Hedrick, R.P. 2002. Initial characteristics of Koi herpes virus and development of a polymerase chain reaction assay to detect the virus in koi, Cyprinus carpio koi. Dis. Aquat. Org., 48: 101–108.
Gray, W.L., Mullis, L., LaPatra, S.E., Groff, J.M. & Goodwin, A. 2002. Detection of Koi herpes virus DNA in tissues of infected fish. J. Fish Dis., 25: 171–178.
Hedrick, R.P., Gilad, O., Yun, S., Spangenberg, J.V., Marty, G.D., Nordhausen, R.W., Kebus, M.J., Bercovier, H. & Eldar, A. 2000. A herpes virus associated with mass mortality of juvenile and adult koi, a strain of common carp. J. Aquat. Anim. Health, 12: 44–57.
Perelberg, A., Smirnov, M., Hutoran, M., Diamant, A., Bejerano, Y. & Kotler, M. 2003. Epidemiological description of a new viral disease afflicting cultured Cyprinus carpio in Israel. Israeli J. Aquacult. - Bamidgeh, 55: 5–12.
Tu, C., Weng, M.-C., Shiau, J.-R. & Lin, S.-Y. 2004. Detection of Koi herpes virus in koi Cyprinus carpio in Taiwan. Fish Pathol., 39: 109–110.